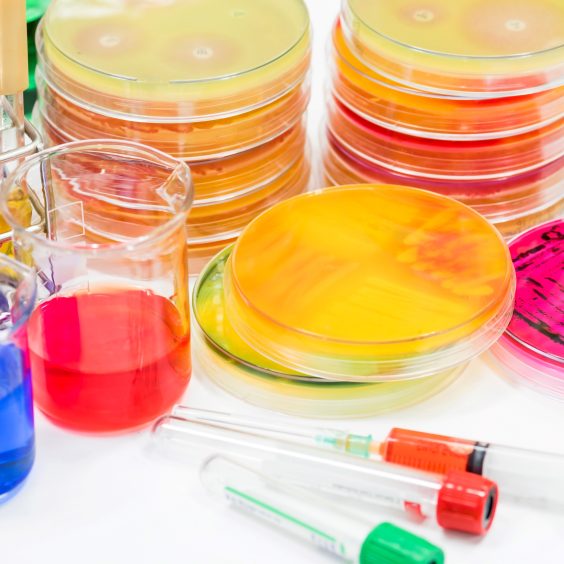
bioch

Cell Biology
These products are essential tools used in research, diagnostics, and biotechnology to study the structure, function, and interactions of biological molecules such as DNA, RNA, and proteins. These products include a wide range of reagents, kits, instruments, and software designed for applications like DNA/RNA extraction, amplification (PCR), sequencing, cloning, gene expression analysis, and protein purification.


Chromatography
Chromatography resin products are specialized materials used in the separation and purification of biomolecules, chemicals, and other compounds. These resins are typically packed into chromatography columns and function based on their selective affinity for target substances. They come in various types, including ion exchange, affinity, and size exclusion resins, each designed for specific applications.
Molecular Biology
These products are essential tools used in research, diagnostics, and biotechnology to study the structure, function, and interactions of biological molecules such as DNA, RNA, and proteins. These products include a wide range of reagents, kits, instruments, and software designed for applications like DNA/RNA extraction, amplification (PCR), sequencing, cloning, gene expression analysis, and protein purification.


IVD Reagents
Biochemicals used in biotechnology are essential components for various scientific applications, from medical research to industrial processes. These include enzymes, buffers, amino acids, nucleotides, and growth factors, which play key roles in cell culture, genetic engineering, and molecular biology. Enzymes are used to catalyze reactions, while amino acids and growth factors support cell growth and differentiation. Buffers maintain pH levels in biological systems, ensuring optimal reaction conditions. on.
Protein Biology
These products encompass a wide range of tools and reagents designed to study proteins’ structure, function, and interactions in biological systems. These products are essential for researchers in fields such as molecular biology, biochemistry, and cell biology. They include antibodies, enzymes, protein markers, and kits for protein extraction, quantification, and purification. Additionally, protein biology products often feature specialized assays for detecting protein-protein interactions, post-translational modifications, and enzyme activity.

Biochemicals
Biochemicals used in biotechnology are essential components for various scientific applications, from medical research to industrial processes. These include enzymes, buffers, amino acids, nucleotides, and growth factors, which play key roles in cell culture, genetic engineering, and molecular biology. Enzymes are used to catalyze reactions, while amino acids and growth factors support cell growth and differentiation. Buffers maintain pH levels in biological systems, ensuring optimal reaction conditions. on.


